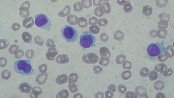

What is hairy cell leukemia? Hairy cell leukemia (abbreviated as HCL) is a rare cancer of the blood and bone marrow. In this form of cancer, certain types of white blood cells, called B-lymphocyte cells, are affected. Hairy cell leukemia is characterized by the uninhibited growth of these B-lymphocytes and low numbers of other normal blood cells. The abnormal cells have fine outgrowths on their surface giving them a hairy look when viewed with a microscope, which is the reason for the name of the condition. How common is hairy cell leukemia? HCL is relatively uncommon and makes up just 2% of all leukemia (cancer of the blood) cases. Less than 1000 new cases of hairy cell leukemia are diagnosed annually in the United States. However, there is an extremely low incidence of hairy cell leukemia in Japan and in people of African descent. Hairy cell leukemia is more common in males, who are 4 to 5 times more likely to develop this cancer. It mostly affects middle-aged men in their 50s. What happens in hairy cell leukemia? The abnormal lymphocyte in hairy cell leukemia is a specific clone or type of B-cells. The abnormal cells infiltrate the reticuloendothelial system, which … Continue reading Hairy Cell Leukemia (HCL)